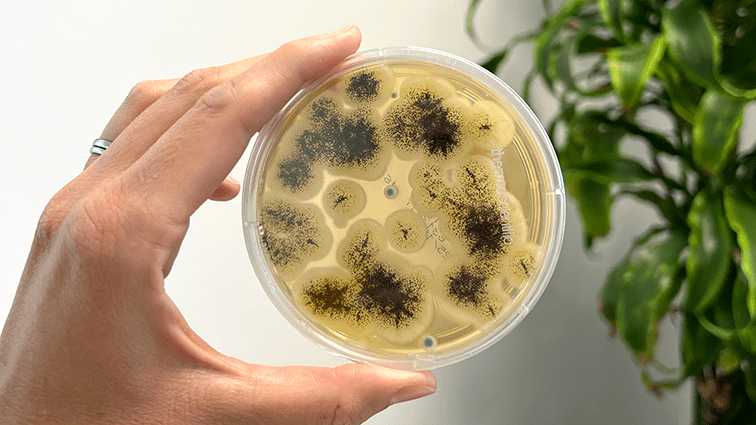

Baubiologie München
Raum für Gesundheit.
Als Baubiologin finde ich heraus, ob und wie Umweltfaktoren deine Gesundheit beeinflussen. Durch baubiologische Messung, fachliche Analyse und persönliche Beratung entwickelst du Verständnis für deine Umgebung und was du konkret verändern kannst.
Baubiologie München
Raum für Gesundheit.
Als Baubiologin finde ich heraus, ob und wie Umweltfaktoren deine Gesundheit beeinflussen. Durch baubiologische Messung, fachliche Analyse und persönliche Beratung entwickelst du Verständnis für deine Umgebung und was du konkret verändern kannst.
Gesund wohnen – bewusst Leben.
Wir kümmern uns um Ernährung, Bewegung und Entspannung aber wie oft hinterfragen wir eigentlich die Räume, in denen wir leben und arbeiten?
Unsere Umgebung prägt unsere Gesundheit täglich, ob wir es merken oder nicht.
DES TAGES
verbringen wir in geschlossenen Räumen.
Luft
atmen wir tagtäglich ein.
AM TAG
sind wir von Elektrosmog umgeben.
Gesundes Wohnen ist messbar
Mit mir arbeiten
Meine Leistungen
Kopfschmerzen, Schlafprobleme, Erschöpfung oder ein diffuses Krankheitsgefühl in den eigenen vier Wänden oder im Büro?
Vielleicht riecht es immer wieder unangenehm, dunkle Flecken an Wänden sind sichtbar oder der nächste Mobilfunkmast ist nicht weit entfernt.
Solche Beobachtungen können auf versteckte Belastungen hinweisen – ob durch Schadstoffe, elektromagnetische Felder oder mikrobielle Quellen wie Schimmel oder Bakterien. Ob aus aktuellem Anlass oder rein vorsorglich stellt sich die Frage: Kann meine Umgebung mit meiner Gesundheit zusammenhängen?
Meine baubiologischen Untersuchungen unterstützen Privatpersonen, öffentlichen Einrichtungen und Unternehmen dabei, genau hinzuschauen.

Felder I Wellen I Strahlung
Gemessen werden hochfrequente und niederfrequente elektrische Felder, z. B. durch WLAN, Mobilfunk, Stromleitungen oder elektrische Geräte. Deren Intensität wird bewertet und die jeweiligen Quellen lokalisiert.

Wohngifte I Schadstoffe I Raumklima
Untersuchungen zeigen, ob und in welchem Ausmaß Schadstoffe in der Raumluft, im Hausstaub oder in Materialien vorhanden sind z. B. Weichmacher, Formaldehyd oder VOC. Die Ergebnisse werden fachlich eingeordnet.
Pilze I Bakterien I Allergene
Bei Verdacht auf Schimmel, mikrobielle Belastungen oder allergieauslösende Stoffe werden Luft oder Oberflächen gezielt untersucht. Die Auswertung zeigt, ob Handlungsbedarf besteht und wie die Situation verbessert werden kann.
Vorteile unserer Zusammenarbeit
In einer Welt voller Informationen und Möglichkeiten ist meine Herangehensweise zielgerichtet. Mein ganzheitlicher Blick stellt die Zusammenhänge und Wechselwirkungen in den Mittelpunkt und nicht nur einzelne Faktoren. Wichtig ist mir, dass Lösungen in deinem Alltag wirklich funktionieren. Deshalb entwickle ich individuelle Ansätze, die zu dir, deiner Familie oder deinem Arbeitsplatz passen.
Meine QUALITÄTSSTANDARDS
Kundenbewertungen
Sie sehen gerade einen Platzhalterinhalt von TrustIndex. Um auf den eigentlichen Inhalt zuzugreifen, klicken Sie auf die Schaltfläche unten. Bitte beachten Sie, dass dabei Daten an Drittanbieter weitergegeben werden.
Mehr Informationen
Cathleen Engelke
Über mich
Ich bin Cathleen, Baubiologin IBN und Messtechnikerin mit einem feinen Gespür für unsere Umgebung.
Als sensibler Mensch weiß ich, wie stark unser Umfeld die Gesundheit und das Wohlbefinden beeinflusst. Ob zur Ursachenklärung oder als bewusste Prävention: Ich messe, analysiere und begleite – für gesunde Innenräume.
Welche Rolle spielt die Baubiologie dabei?
Die Baubiologie ist der Schlüssel, wenn es darum geht, Wohnräume wirklich ganzheitlich zu betrachten. Sie rückt die Wechselwirkungen zwischen Mensch und gebauter Umwelt in den Fokus und eröffnet damit eine neue Perspektive auf unsere Gesundheit. Durch baubiologische Messungen werden unsichtbare Einflüsse überhaupt erst greifbar. So entsteht eine fundierte Grundlage, um gezielt Veränderungen vorzunehmen.
In der folgenden interaktiven Grafik sind typische Belastungen von Schadstoffen und Elektrosmog in Innenräumen beispielhaft dargestellt.



























Aktuelles & Wissenswertes
-
Schlafplatzuntersuchung: Umweltfaktoren erkennen & besser schlafen
Schlaflose Nächte – ein Problem, das immer mehr Menschen betrifft. Jeder zweite kämpft mit Einschlafproblemen, unruhigem Schlaf oder ständiger Müdigkeit. Dabei ist erholsamer Schlaf essenziell für unsere Gesundheit, denn in der Nacht regeneriert der Körper, verarbeitet Erlebtes und sammelt neue Energie.
-
Elektrosmog – Klarheit im Strahlendschungel
Ich liebe Technik – wie wir alle. Sie schenkt uns Komfort, verbindet uns und erleichtert unseren Alltag. In meiner Arbeit als Baubiologin geht es deshalb nicht darum, Technik zu vermeiden, sondern bewusst damit umzugehen. Besonders an einem Ort, an dem unser Körper Ruhe braucht: dem Schlafplatz. Dort regeneriert sich unser Organismus, verarbeitet Eindrücke und schöpft…
-
Formaldehyd in Innenräumen
Es gibt Substanzen, die sieht man nicht und doch haben sie eine enorme Wirkung auf unser Wohlbefinden. Formaldehyd ist genau so ein Fall. Ein gasförmiger Stoff, der oft unbemerkt in der Raumluft schwebt und über viele Jahre hinweg gesundheitlich belastend sein kann. Als Baubiologin stoße ich bei meiner Arbeit regelmäßig auf diesen versteckten Mitbewohner –…